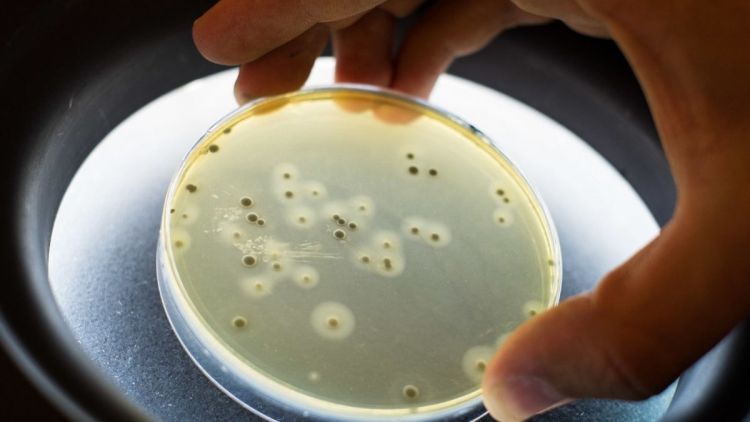
Pesquisadores da USP e UNESP descobrem enzimas que ajudam antibióticos a vencer bactéria resistente

SÃO CARLOS/SP - Cientistas do Instituto de Física de São Carlos (IFSC/USP) e da UNESP descobriram duas enzimas capazes de “quebrar” a proteção de uma bactéria perigosa e, com isso, fazer um antibiótico voltar a funcionar melhor. A pesquisa traz uma nova esperança no combate a infecções difíceis de tratar, tanto em pessoas quanto em animais.
A bactéria estudada é a Staphylococcus aureus, responsável por problemas como infecções na pele, no pulmão, no sangue e até em próteses médicas. Em vacas, ela também pode causar mastite, uma inflamação nas mamas que gera prejuízos na produção de leite.
Um dos motivos que tornam essa bactéria tão difícil de eliminar é que ela forma uma espécie de camada protetora chamada “biofilme”. Imagine um “lodo invisível” onde as bactérias ficam grudadas e escondidas. Essa camada dificulta a ação dos antibióticos e também a defesa do próprio organismo.
Os pesquisadores focaram em um tipo de “cola” presente nesse biofilme, feito principalmente de uma substância açucarada. As duas enzimas estudadas conseguem cortar justamente essa “cola”, desmontando a estrutura que protege as bactérias.
Duas enzimas com efeito poderoso
As enzimas, chamadas ApGH20 e ChGH20, foram produzidas em laboratório. Quando aplicadas sobre os biofilmes da bactéria, elas conseguiram destruir grande parte dessa camada protetora. Uma delas, a ApGH20, foi muito mais eficiente, precisando de uma quantidade bem menor para ter efeito.
Imagens feitas com microscópio mostraram que, depois do tratamento, o biofilme praticamente desaparecia, deixando as bactérias mais expostas.
O resultado mais animador apareceu quando as enzimas foram usadas junto com o antibiótico gentamicina.
Sozinho, o remédio quase não conseguia matar as bactérias protegidas pelo biofilme, mesmo em doses altas. Mas, depois que o biofilme foi enfraquecido pelas enzimas, o antibiótico passou a funcionar muito melhor. Doses bem menores já foram suficientes para eliminar as bactérias — pelo menos 16 vezes menores do que antes.
Isso acontece porque, sem a “capa protetora”, o medicamento consegue finalmente alcançar as bactérias.
Além de uma bactéria isolada de um paciente humano, os cientistas também testaram o método em bactérias vindas de casos de mastite em vacas. As enzimas também ajudaram a reduzir os biofilmes nesses casos, embora com resultados variados, já que alguns biofilmes tinham outros tipos de material além da “cola” açucarada.
Uma nova estratégia contra a resistência
Com o aumento das bactérias resistentes e a falta de novos antibióticos no mercado, a ideia de ajudar os remédios antigos a funcionarem melhor ganha força. Em vez de substituir os antibióticos, as enzimas atuariam como aliadas, removendo a proteção das bactérias.
Os pesquisadores destacam que os testes ainda foram feitos em laboratório. Os próximos passos envolvem estudos para verificar segurança e eficácia em organismos vivos. Mesmo assim, os resultados indicam um caminho promissor para tratar infecções difíceis causadas por biofilmes bacterianos.
Esta pesquisa foi divulgada na revista científica “Acta Biomaterialia”, tendo como autores Andrei Nicoli Gebieluca Dabul, Lorgio Victor Bautista Samaniego, Anelyse Abreu Cortez, Samuel Luis Scandelau, Marcelo Vizon´a Liberato, Agatha MS Kubo Ana Beatriz Rodrigues, Rejane MT Grotto, Guilherme Valente, Vera Lúcia Mores Rall, Sebastião Pratavieira, Mario de Oliveira Neto, Carla Raquel Fontana e Igor Polikarpov (pesquisador correspondente).
Clique no link a seguir para acessar este estudo - https://www2.ifsc.usp.br/portal-ifsc/wp-content/uploads/2026/01/main.pdf